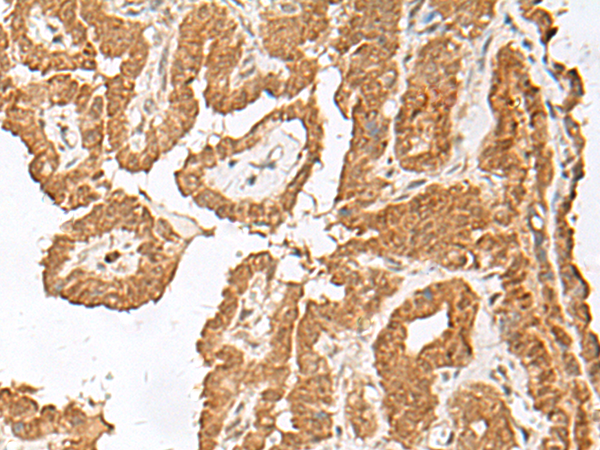

|
Background: |
The protein encoded by this gene is a member of the fibroblast growth factor (FGF) family. FGF family members possess broad mitogenic and cell survival activities, and are involved in a variety of biological processes, including embryonic development, cell growth, morphogenesis, tissue repair, tumor growth, and invasion. This gene is located in a region on chromosome X, which is associated with Borjeson-Forssman-Lehmann syndrome (BFLS), making it a possible candidate gene for familial cases of the BFLS, and for other syndromal and nonspecific forms of X-linked mental retardation mapping to this region. Alternative splicing of this gene at the 5' end results in several transcript variants encoding different isoforms with different N-termini. |
|
Applications: |
ELISA, IHC |
|
Name of antibody: |
FGF13 |
|
Immunogen: |
Synthetic peptide of human FGF13 |
|
Full name: |
fibroblast growth factor 13 |
|
Synonyms: |
FGF2; FHF2; FHF-2; FGF-13 |
|
SwissProt: |
Q92913 |
|
ELISA Recommended dilution: |
5000-10000 |
|
IHC positive control: |
Human esophagus cancer and Human thyroid cancer |
|
IHC Recommend dilution: |
40-200 |
購物車
幫助
021-54845833/15800441009
